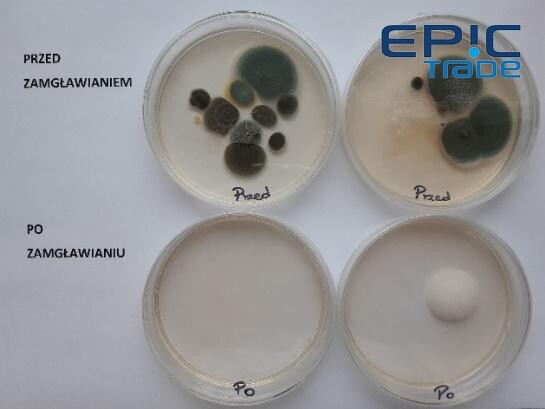

Nowa broń w walce z koronawirusem

Jest już dostępna w Polsce nowa technologia zwalczająca wirusa SARS CoV-2 oparta na wytwarzanym w organizmie naturalnym składniku, który jest ważnym elementem systemu odpornościowego ludzi i zwierząt. Wysoka biozgodność tej substancji pozwala na bezpieczną dezynfekcję zarówno w przemyśle, obszarach publicznych jak i w naszych domach. Skuteczność została potwierdzona na podstawie światowych i polskich badań. Zobacz zdjęcia udostępnione przez firmę EPIC z Elbląga.
Wybór środka dezynfekującego
W związku z tym, że najprawdopodobniej na wiele lat będziemy musieli się zaprzyjaźnić z dezynfekcją, powinniśmy wybierać takie rozwiązania, które są przede wszystkim skuteczne w zwalczaniu szkodliwych mikroorganizmów. Bardzo ważnym jest jednak także, aby rozwiązania te nie miały negatywnego wpływu na ludzi, zwierzęta jak i na środowisko naturalne. Okazuje się, że istnieje taka substancja jak Hypochlorous acid (Kwas podchlorawy), która skutecznie zwalcza wirusy, bakterie i grzyby. Substancja ta jest naturalnie wytwarzana przez organizm ludzi i zwierząt.
Naturalna substancja, która wspiera naszą odporność
Kwas podchlorawy posiada ekstremalnie wysoką biozgodność, wynikającą z naturalnego udziału tej substancji w procesie nieswoistej odporności organizmu - jest to swego rodzaju pierwsza linia obrony, która zapobiega wtargnięciu drobnoustrojom do organizmu. Kwas podchlorawy wytwarzany jest przez neutrofile (białe ciałka krwi) w wyniku reakcji na urazy oraz zakażenie . Wykorzystywany jest przez organizm do zwalczania stanów zapalnych i infekcji chorobowych. Kwas podchlorawy jest więc ważnym składnikiem naszego systemu odpornościowego.
Bio actiw: polski środek biobójczy na bazie kwasu podchlorawego
Poza organizmem zwierząt i ludzi, kwas podchlorawy wytwarza się w specjalnych generatorach w wyniku elektrolizy soli kuchennej i wody. Na świecie substancję tą często nazywa się Elektrolizowaną wodą (EW), lub: Elektrochemicznie aktywowaną wodą (ECA). Główną substancją czynną powstałą w tym procesie jest właśnie kwas podchlorawy (HOCl). Jest nieszkodliwy dla ludzi, zwierząt i środowiska naturalnego. Substancja ta jest stosowana powszechnie w Japonii, USA, Kanadzie, Australii: w przemyśle medycznym, dentystycznym, spożywczym, rolnictwie i przemyśle mleczarskim. Jest szeroko stosowana do dezynfekcji w japońskich i rosyjskich szpitalach i klinikach dentystycznych. W marcu 2020 roku kwas podchlorawy został oficjalnie zatwierdzony w USA do walki z koronawirusem.
Woda elektrolizowana powstająca z generatorów jest niestabilna i nadaje się do użycia najwyżej przez kilka tygodni. Do grona niewielu firm na świecie, które opracowały technologię produkcji stabilnego kwasu podchlorawego dołączył w 2020 roku polski start up - firma BIO ACTIW sp. z o.o. Zarejestrowała ona produkt biobójczy: Bio ActiW 500 na bazie ultra czystego kwasu podchlorawego. Produkt jest dopuszczony do powszechnego stosowania, w tym do dezynfekcji powierzchni, dezynfekcji wody do picia oraz nawet do dezynfekcji owoców i warzyw.
Skuteczność potwierdzona badaniami
Działanie bakteriobójcze i wirusobójcze kwasu podchlorawego potwierdzone jest na podstawie bardzo wielu badań światowych. Pierwsze polskie badania tej substancji na wirusach zostały wykonane we wrześniu 2020 roku. Testy laboratoryjne wykazały bardzo dużą skuteczność, aż 99,99999% wobec szczepów wirusów: Poliovirus type 1, LSc 2ab, Murine norovirus, Adenovirus type 5, Vaccinia virus strain Elstree (wirus testowy wobec koronawirusa: SARS CoV-2) przy stężeniu roztworu Bio ActiW: 0,02% (200 ppm) w czasie 15 minut. Przy stężeniu: 0,03% (300 ppm) – w ciągu minuty. Badania zostały wykonane według normy PN-EN 14476.
Niewidoczne zagrożenie w powietrzu
W lipcu 2020 roku WHO podało wyniki badań, że SARS CoV – 2 znajdujący się w bardzo małych cząstkach o średnicy do 5,0 mikronów może być zawieszony w powietrzu do 19 godzin i może być przenoszony na duże odległości.
Wyniki australijskich badań opublikowanych 7 października 2020 roku w Virology Jurnal wykazały, że ludzie najczęściej zakażają się wirusem, kiedy rozmawiają, kaszlą lub kichają. Testy wykazały jednak, że transmisja odbywa się również za pomocą cząstek zawieszonych w powietrzu. Eksperci z CSIRO wykonujący te badania, stwierdzili również, że koronawirus jest zdolny przetrwać na gładkich powierzchniach nawet do 28 dni.
Na podstawie powyższych badań wynika, że najskuteczniejszą metodą dezynfekcji pomieszczeń powinno być odkażenie całej przestrzeni (powierzchni powietrza). Dodatkowo za takim sposobem odkażania przemawiają inne wyniki badań (Park et al. 2007) i (Moorman et al. 2017). które wykazały, że zamgławianie jest znacznie bardziej skuteczne w eliminowaniu wirusów z powierzchni niż przecieranie ściereczką ze środkiem biobójczym, ze względu na znajdujące się na powierzchniach nanorysy, w których mogą znajdować się wirusy.
W powietrzu mogą znajdować się bakterie, grzyby, wirusy. Najliczniej reprezentowaną grupą czynników chorobotwórczych przenoszonych drogą powietrzno-pyłową lub powietrzno-kropelkową są wirusy (Lewandowski R, Jóźwik P., 2017).
Zwalcza koronawirusa i inne patogeny przez zamgławianie
Polskie firmy Bio ActiW i BioMedAqua jako jedne z pierwszych firm na świecie zleciły badania, które miały sprawdzić czy kwas podchlorawy jest w stanie zwalczać koronawirusa poprzez zamgławianie, tak zwaną suchą mgłą - w krótkim czasie i w warunkach bezpiecznych dla człowieka. Badania zostały wykonane na produkcie Bio ActiW (stężenie 0,02%) we wrześniu 2020 roku w Państwowym Instytucie Badawczym – PIWet- Państwowy Instytut Weterynaryjny w Puławach. Wykazały one, że w czasie dezynfekcji (poprzez zamgławianie) maseczki z naniesionym koronawirusem (PEDV) wynoszącym tylko 60 sekund, działanie wirusobójcze wyniosło już 90-92%. W takich warunkach zamgławiania, maksymalny poziom chloru w kabinie dezynfekcyjnej, w której prowadzone były badania nie przekraczał 0,7 mg/1 m³ (fot.2). Zgodnie z Rozporządzenia Ministra Rodziny, Pracy i Polityki Socjalnej Ministra Pracy z dnia 12 czerwca 2018 roku - takie stężenie chloru jest nieszkodliwe dla ludzi .
Badania laboratoryjne wykonane w maju i listopadzie 2020 roku według nowej normy EN 17272 (dezynfekcja poprzez zamgławianie), wykazały bardzo dużą skuteczność: ponad 99,9999%. roztworu Bio ActiW w zwalczaniu groźnej bakterii chorobotwórczej: Staphylococcus aureus, umieszczonej na metalowych płytkach oddalonych kilka metrów od urządzenia zamgławiającego.
Inne badania wykonane w listopadzie 2020 roku przez firmę Agro Smart Lab wykazały dużą skuteczność w zwalczaniu w powietrzu bakterii i grzybów (w tym Penicillium czy Clado (fot. 3).sporium, których zarodniki są bardzo alergenne) w warunkach biurowych poprzez zamgławianiem produktem Bio ActiW. W jednych i drugich badaniach użyto większą ilość środka na 1 m³ niż w badaniach w Państwowym Instytucie Badawczym PIWet. Nie zostało jednak przekroczone NDSCh (Najwyższe Dopuszczalne Stężenie Chwilowe) dla chloru, wynoszące 1,5 mg/1 m³.
Bezpieczny dla ludzi i środowiska
Bio ActiW 500 posiada Świadectwo Jakości Zdrowotnej (P-BŻ-6071-06/20/G) wydany przez Narodowy Instytut Zdrowia Publicznego zaświadczający, że produkt o zadeklarowanym przez producenta składzie, przeznaczeniu i sposobie użycia nie stanowi zagrożenia dla zdrowia człowieka.
Bio ActiW 500 posiada Atest Higieniczny (B-BK-60210-0825/20) wydany przez Narodowy Instytut Zdrowia Publicznego zaświadczający, że produkt nadaje się do dezynfekcji wody przeznaczonej do picia dla ludzi i zwierząt. Przeprowadzone badanie dermatologiczne na grupie 25 ochotników nie wykazało wystąpienia alergii na substancję aktywną. Potwierdza to, że środek jest dobrze tolerowany przez skórę i nie wykazuje właściwości drażniących, ani uczulających. Badania przeprowadzone w specjalistycznym laboratorium metodą h-RIPT.
Ochrona przed koronawirusem i innymi chorobotwórczymi patogenami w miejscu pracy i w domu
Powyższe wyniki badań wskazują, że można w bezpieczny sposób ograniczać ryzyko związane z infekcją wirusa SARS CoV- 2 czy innymi chorobotwórczymi wirusami, bakteriami lub grzybami. Aby dezynfekcja poprzez zamgławianie była skuteczna, musi być wykonana za pomocą urządzeń, które wytwarzają odpowiedniej wielkości krople (poniżej 10 mikronów). Takie mikrokrople tworzą tzw. suchą mgłę. Nie powoduje one zawilgocenia powierzchni, gdyż tak małe krople zachowują się podobnie jak gaz, nie przylegają do powierzchni, ale się od niej odbijają. Dzięki temu dezynfekcja powietrza i powierzchni za pomocą suchej mgły jest bardzo skuteczna, ponieważ kwas podchlorawy unosi się długo w powietrzu i dociera do każdego miejsca w pomieszczeniu zabijając po drodze patogeny.
Pełna dezynfekcja
Do dezynfekcji za pomocą suchej mgły można używać specjalne urządzenia wytwarzające mikrokrople za pomocą dysz powietrzno-wodnych, lub zamgławiacze ultradzwiękowe, czy nawet nawilżacze ultradźwiękowe, ale te ostatnie nadają się tylko do małych powierzchni.
W powyższych badaniach laboratoryjnych, gdzie wykazano bardzo dużą redukcję patogenów zastosowano około 500 ml roztworu Bio ActiW o stężeniu 0,02% na każde/10 m². Taką ilość środka zalecamy do przeprowadzania pełnej dezynfekcji pomieszczeń, gdzie przebywali chorzy ludzie lub osoby były na kwarantannie. Warto również stosować taką formę dezynfekcji w szatniach, gdzie ludzie przebywają tylko kilka minut. Przy takiej ilości środka zawartość chloru w powietrzu może przekraczać 0,7 mg/ mg/1m³, ale nigdy nie przekracza 1,5 mg/1m³. Oznacza to że nie jest przekroczone Najwyższe Dopuszczalne Stężenie Chwilowe (NDSCh). Zgodnie z Rozporządzeniem z 12 czerwca 2018 roku, w takich warunkach pracownik może przebywać do 15 minut bez negatywnego wpływu na zdrowie. W warunkach domowych można wykonać taka pełną dezynfekcję, ale musi być odpowiedniej wydajności zamgławiacz czy nawilżacz. Podczas zamgławiania i godzinę po procesie dezynfekcji pokój musi być zamknięty. Nie należy przebywać w takim pokoju, chociaż kilkuminutowy pobyt jest dopuszczalny. Po procesie dezynfekcji pokój należy przewietrzyć.
Prewencyjna dezynfekcja
W standardowych warunkach domowych warto przeprowadzać cyklicznie oczyszczanie powietrza i powierzchni z patogenów przy użyciu zamgławiania produktem Bio ActiW (fot. 7). Do tego celu mogą być już wykorzystywane zwykłe nawilżacze ultradźwiękowe, gdyż potrzebna jest mniejsza ilość roztworu.. Wystarczy zastosować około 250 ml roztworu Bio ActiW o stężeniu 0,02% aktywnego chloru na każde 10 m² (Taka ilość, jaka była zastosowana podczas badań w Państwowym Instytucie badawczym PIWet). Stosując taką dawkę Najwyższe Dopuszczalne Stężenie (NDS) chloru w powietrzu nigdy nie przekracza 0,7 mg/1m³. Co ważne, zgodnie z Rozporządzeniem z 12 czerwca 2018 roku, przy takiej ilości chloru można przebywać w pomieszczeniu bez negatywnego wpływu na zdrowie. Oczywiście nie zalecamy przebywania cały czas w zamgławianym pokoju, ale kilkunastominutowy pobyt pozwala zredukować szkodliwe mikroorganizmy również z powierzchni naszych ubrań oraz ze skóry. Ważnym jest aby podczas aplikacji środka i godzinę po zakończeniu zamgławiania, pomieszczenie było zamknięte. Wtedy skuteczność jest największa. Następnie pokój należy przewietrzyć.
Więcej informacji o produkcie, innych zastosowaniach oraz kontakty do partnerów handlowych można znaleźć na stronie internetowej bioaktiw.
Rabat po elbląsku
Przy zamówieniach mailowych z dopiskiem "BioActiw ELBLĄG” na adres trade@epic.biz.pl, oferujemy rabat 5% od cen producenta z dowozem do domu lub firmy na terenie Elbląga. Koszty dostawy wliczone w ceną.Dostawy realizowane 2 razy w tygodniu.
Firma EPIC Trade dostarcza profesjonalne BRAMY DEZYNFEKCYJNE z pomiarem temperatury i obecnością maseczki, jak dodatkowe zabezpieczenie zakładów pracy i użyteczności publicznej. Metodą poprzez zamgławianie (środkami BioActiw) dezynfekowane jest 100% ubrań osób przechodzących. Bramy są dostępne w Elblągu. Zapraszam na prezentację.
Nasza firma wykonuje również BEZPIECZNE DEZYNFEKCJE biur, szkół, mieszkań, magazynów poprzez zamgławianie. Przykładowa cena dezynfekcji biura lub mieszkania o powierzchni do 50 m2 wynosi 99,00 PLN brutto.
Zapraszamy Dyrektorów szkół do współpracy, oferujemy wsparcie merytoryczne w przygotowaniu placówek do powrotu uczniów do szkół.
Zapraszam do bezpośredniego kontaktu z nami
tel: +48 539 629 111
Dostarczamy opisywane środki dezynfekcyjne i wykonujemy pełne dezynfekcje pomieszczeń
Dodatkowo nasza oferta na allegro
mgr inż. Mirosław Maziarka
prezes firmy Agro Smart Lab sp. z o.o.
Współzałożyciel firmy Bio ActiW sp. z o.o.
dyrektor ds. Badań i Rozwoju w firmie Bio Actiw sp. z o.o.
---- artykuł promocyjny -----